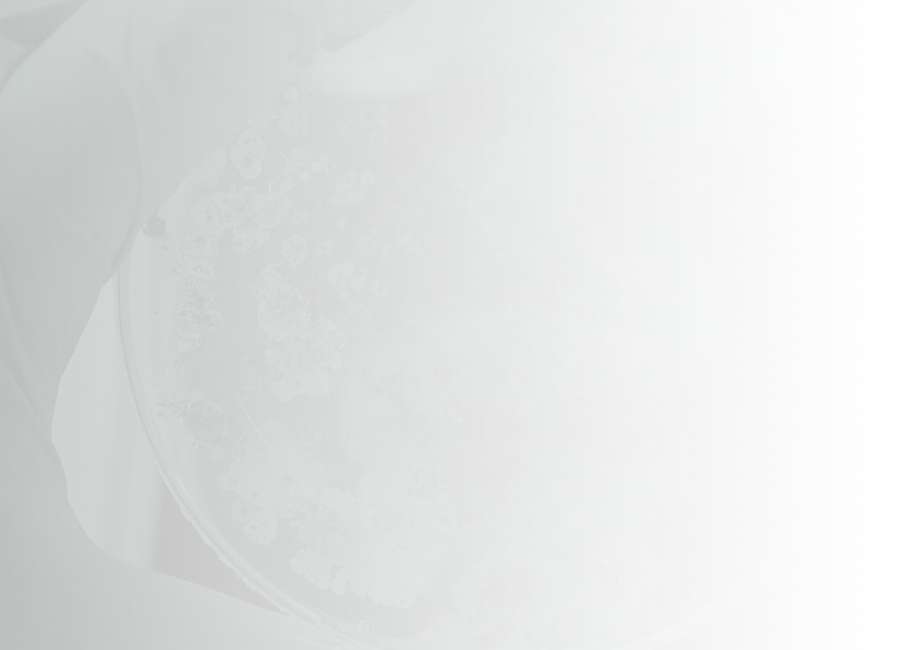
Petri dish with microbial growth

Activity Summary
Students will participate in a community expo that informs whānau about infection and control of pathogens.
Assessment Activity Version
3
Assessment Activity Code
C
Achievement Standard
Assessment Hero Image
Assessment Thumbnail

